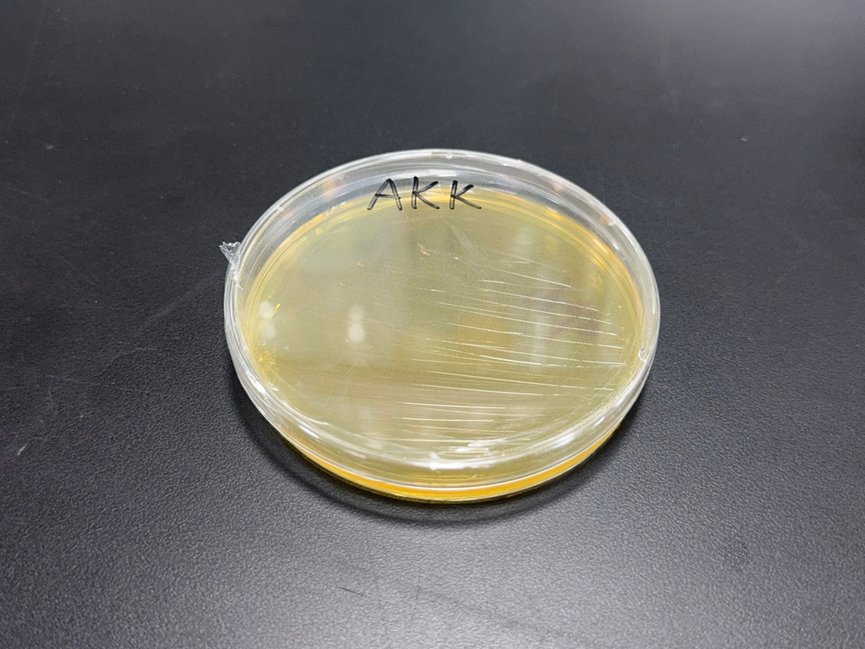

在大健康与美妆原料领域,“科学” 从来不是口号,而是从研发到产业化的每一个可量化、可追溯的环节。2025深圳国际健康与营养保健品展上,广州汉和生命科学有限公司——这家集“国家高新技术企业、广西专精特新企业、国家知识产权优势企业、广西瞪羚企业、广西新型研发机构”等科研与产业荣誉于一身的创新主体,将以“合成生物学驱动的原料科技革命”为核心,展示其在大型食药用真菌发酵、中药发酵、高价值化合物、益生菌领域的“科学级”突破,为行业呈现从实验室创新到工业化落地的完整科研价值闭环。
作为 “科学与科学家” 的践行者,汉和生物的技术底气源于对合成生物学的深度攻坚。在大型食药用真菌发酵领域,其构建的四大液态产品体系(发酵原液、发酵滤液、溶胞产物、提取物粉末),是基于微生物代谢调控、细胞破壁技术、喷雾干燥工艺等多学科交叉的科研成果:
-
发酵原液保留菌丝体与发酵液的原生代谢状态,为菌种活力研究与液体菌种制备提供 “科研级” 样本;
-
发酵滤液通过0.22μm精密过滤实现成分纯化,其浊度、微生物限度等指标完全符合化妆品与大健康饮品的 GMP级要求;
-
溶胞产物采用高剪切均质破壁技术,经粒径分布、活性成分溶出率等检测验证,确保真菌活性物质的充分释放;
-
提取物粉末的喷雾干燥工艺参数(进风温度、出风温度、雾化压力)经过正交试验优化,保证活性成分保留率>90%。
这种 “科研设计 – 工艺优化 – 质量验证” 的全链条逻辑,正是汉和作为 “广西产学研用一体化企业”“数字化车间” 所具备的科研转化能力的直观体现。

技术创新的 “科学性” 更体现在汉和的资质与荣誉矩阵中。ISO9001(质量管理体系)、ISO14001(环境管理体系)、ISO22000(食品安全管理体系)、FSSC22000、HACCP、BRC 等认证,构建了从研发到生产的 “科学级” 品控体系;HALAL、KOSHER 认证则为原料的全球化应用提供了合规性保障。而 “国家知识产权优势企业” 的称号,背后是其在合成生物学领域的专利布局(涵盖菌株改造、发酵工艺、成分分离等关键环节);“广西新型研发机构” 的资质,印证了其与高校、科研院所的深度技术协作。这些 “硬指标” 共同构成了汉和原料的 “科学可信度”。
在新成分与经典产品的技术突破上,汉和始终遵循 “科研循证” 路径。γ-氨基丁酸入选国家工信部生物制造标志性产品名单,并拥有专利技术背书,同时作为行业标准副组长起草单位,主导该领域技术规范的制定。5-氨基乙酰丙酸、α-酮戊二酸钙、γ-氨基丁酸、褐藻寡糖、L-茶氨酸等经典化合物的生产工艺经正交试验优化,达成成本与品质的最优平衡;重组人源胶原蛋白、白藜芦醇等前沿成分的研发依托合成生物学技术,具备工业化放大的可行性。益生菌家族中,Akk菌的活性保持技术经稳定性试验验证,保障产品货架期内的功效稳定性。这些 “科研级” 技术细节,构成了汉和作为科技型企业的核心竞争力。



本次深圳展,汉和生物的展位将成为?“合成生物学技术成果的展示窗口”。其研发团队将现场展示大型食药用真菌发酵的关键技术节点,从菌株筛选的平板培养到工业化发酵罐的参数控制,从原料成分的检测报告到应用场景的解决方案。对关注 “科研级原料” 的行业伙伴而言,这里是一场 “合成生物学技术的深度交流场”—— 你可以直观了解发酵原液的菌丝形态特征,探究溶胞产物的活性成分分布,交流新成分的应用技术要点。


图1 ?大型真菌的溶胞产物
图2 ?大型真菌的溶胞产物
图3 ?嗜粘蛋白阿克曼菌(Akk 菌)菌落图
图4 嗜粘蛋白阿克曼菌(Akk 菌)菌粉图
汉和生物的参展,本质上是一场 “科学价值的传递”。当 “国家高新技术企业”“专精特新” 这些标签与合成生物学的科研成果深度融合,当 “科学与科学家” 的理念贯穿从实验室到市场的每一个环节,汉和正在重新定义大健康与美妆原料的 “科技高度”。2025深圳国际健康与营养保健展,汉和邀您共赴这场 “科学驱动的原料革命”,见证 “中国智造” 在合成生物学领域的科研力量。




欢迎业务联系,关注汉和、
走进科学与科学家的汉和生物!


联系我们